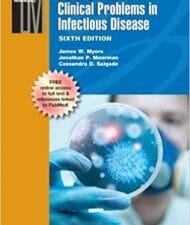
gantz’s manual of clinical problems in infectious disease sixth edition

The most popular reference among physicians for understanding and treating tuberculosis.
- Presents the current science and tools available in the fight against tuberculosis, including drug-resistant forms, from international experts.
- Features the latest preventive strategies, including vaccine development and explores the effect of tuberculosis on organ systems and value of surgery.
- Examines present-day epidemiologic and public health issues, including airline-associated infection, tuberculosis in the developing world, and the role of the World Health Organization and departments of public health.
[amazon asin=1555815138&template=iframe image]
–